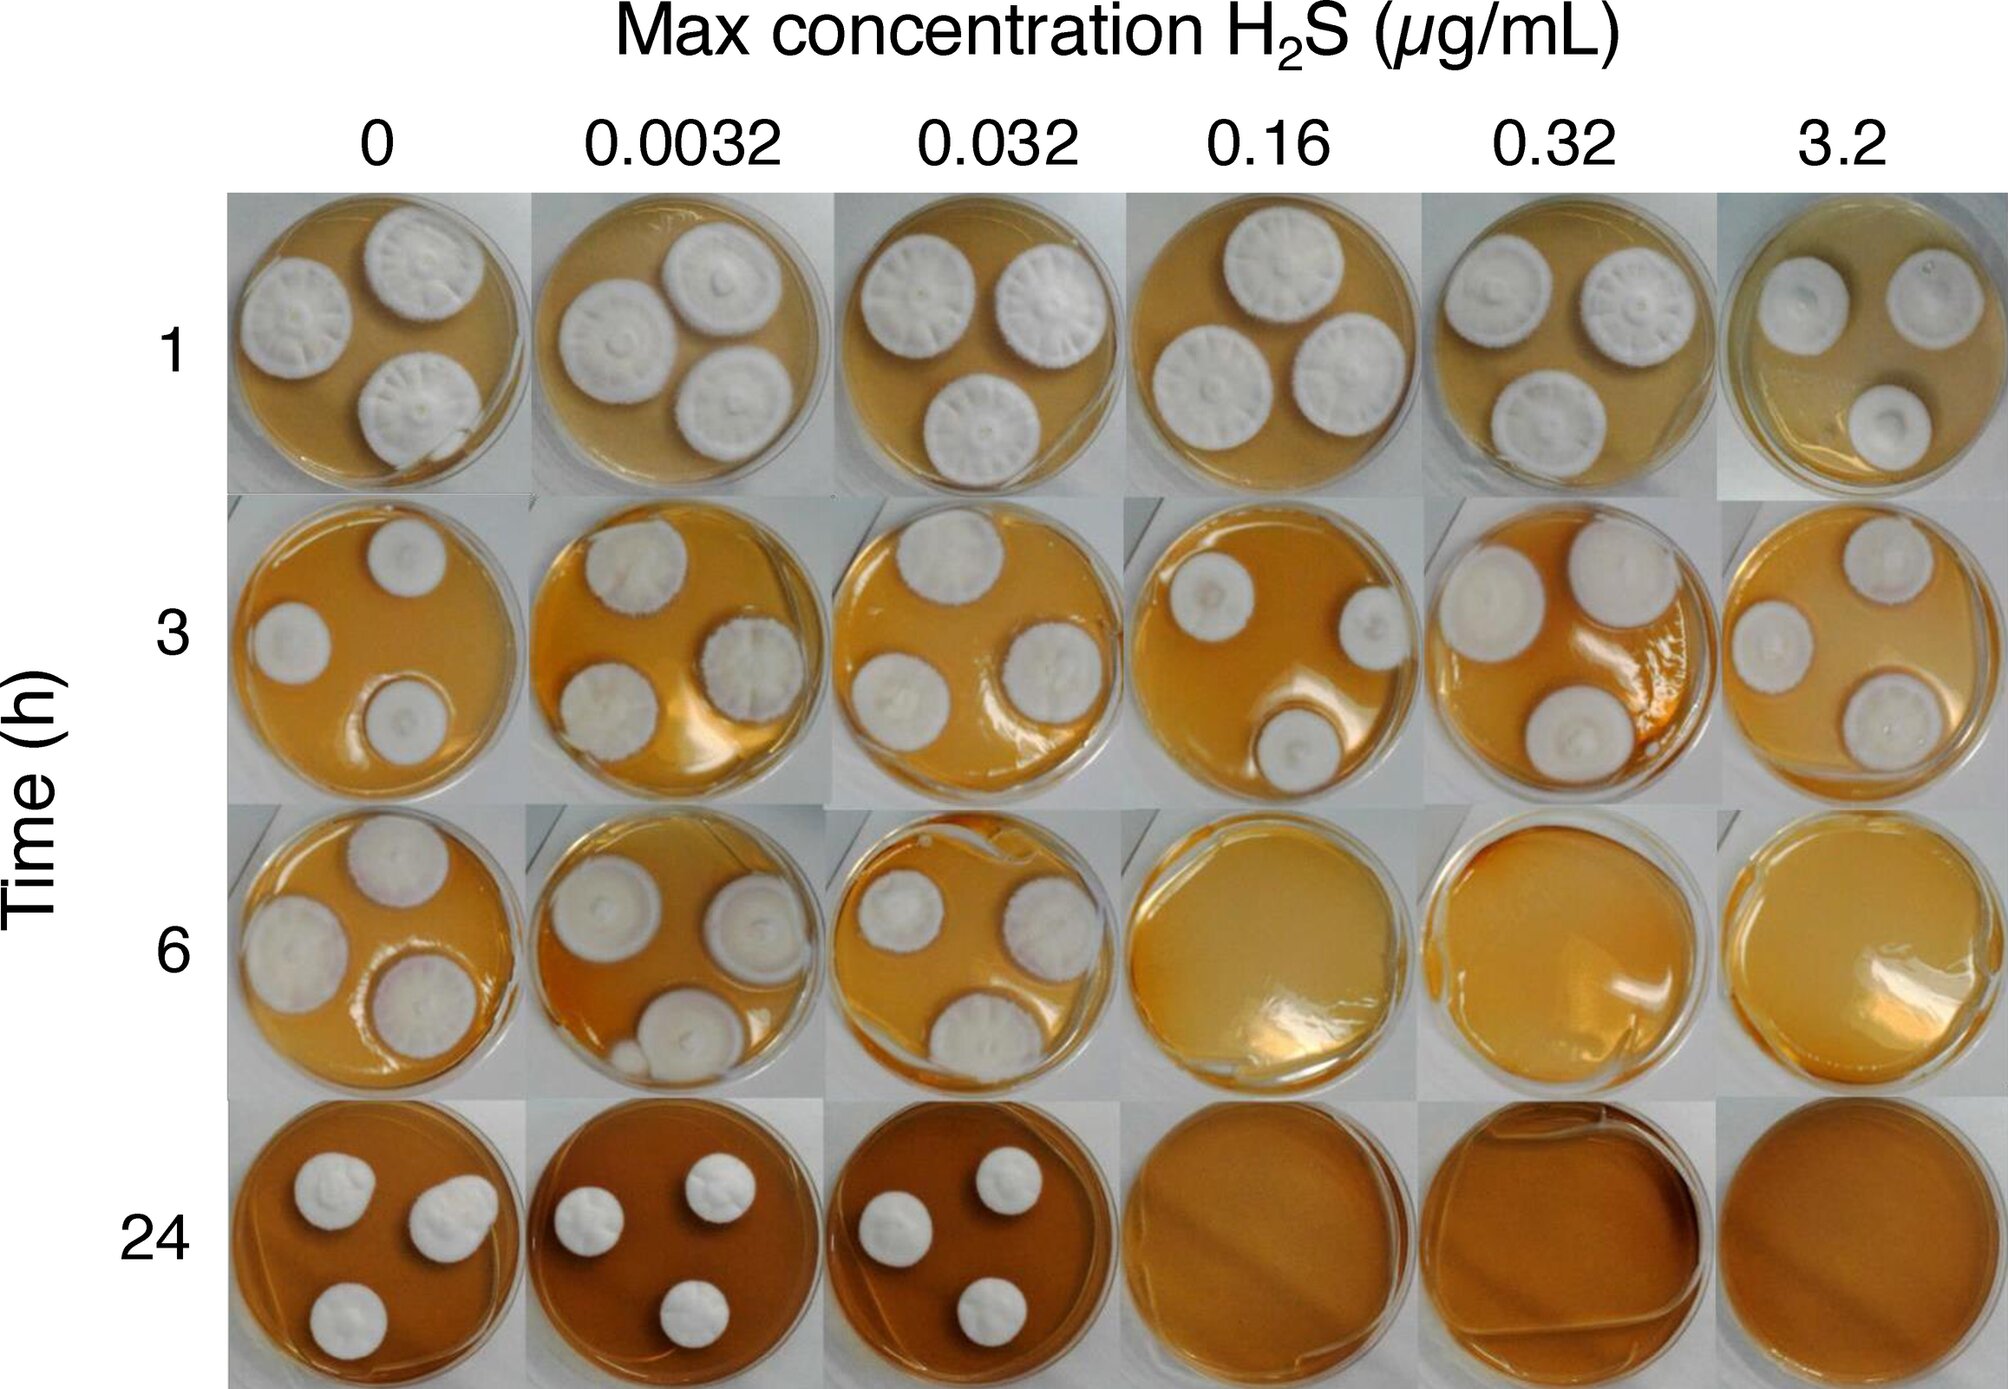
Gás de ‘ovo podre’ pode ser a resposta para tratar infecções nas unhas, dizem cientistas

Exposição à fumaça de incêndio florestal durante a gravidez associada a maior risco de parto prematuro
                Crédito: Unsplash/CC0 Domínio Público
            
Cerca de 10% dos bebês americanos nascem prematuramente. O nascimento antes das 37 semanas pode levar a uma cascata de riscos para a saúde, tanto imediatos como a longo prazo, tornando a prevenção uma ferramenta vital para melhorar a saúde pública ao longo das gerações.
Nos últimos anos, os investigadores identificaram uma ligação potencial entre o fumo dos incêndios florestais – uma das fontes de poluição atmosférica de crescimento mais rápido nos Estados Unidos – e o nascimento prematuro, mas nenhum estudo foi suficientemente grande ou amplo para tirar conclusões definitivas. Um novo estudo liderado pela Universidade de Washington dá um contributo importante, analisando dados de mais de 20 mil nascimentos para descobrir que as grávidas expostas ao fumo dos incêndios florestais têm maior probabilidade de dar à luz prematuramente.
“Prevenir o nascimento prematuro realmente compensa com benefícios duradouros para a saúde futura”, disse a autora principal Allison Sherris, pesquisadora de pós-doutorado da UW em ciências ambientais e de saúde ocupacional. “Também é um mistério. Nem sempre entendemos por que os bebês nascem prematuros, mas sabemos que a poluição do ar contribui para nascimentos prematuros, e faz sentido que a fumaça dos incêndios florestais também o faça. Este estudo ressalta que a fumaça dos incêndios florestais é inseparável da saúde materna e infantil.”
No estudo, publicado em Saúde Planetária da Lancetos pesquisadores usaram dados do programa Influências ambientais nos resultados de saúde infantil (ECHO), um projeto de pesquisa federal focado em como uma ampla gama de fatores ambientais afetam a saúde das crianças. A amostra incluiu 20.034 nascimentos de 2006–2020 nos Estados Unidos contíguos.
Os pesquisadores estimaram a exposição média diária dos participantes a partículas finas (PM2,5) gerada pela fumaça do incêndio florestal e o número total de dias em que estiveram expostos a qualquer quantidade de fumaça. Eles estimaram a intensidade da exposição à fumaça pela frequência com que os participantes foram expostos a PM de incêndios florestais2,5 níveis acima de certos limites.
Eles descobriram que as mulheres grávidas expostas à fumaça mais intensa dos incêndios florestais tinham maior probabilidade de dar à luz prematuramente. No meio da gravidez, a exposição a qualquer fumaça foi associada a um risco elevado de parto prematuro, com pico desse risco por volta da 21ª semana de gestação. No final da gravidez, o risco elevado foi mais intimamente associado à exposição a altas concentrações de PM de incêndios florestais2,5acima de 10 microgramas por metro cúbico.
“O segundo trimestre é um período da gravidez com o crescimento mais rico e intenso da placenta, que por si só é uma parte muito importante da saúde, do crescimento e do desenvolvimento fetal”, disse a coautora Dra. Catherine Karr, professora de ciências ambientais e ocupacionais da UW e de pediatria na Faculdade de Medicina da UW. “Portanto, pode ser que as partículas de fumaça do incêndio estejam realmente interferindo na saúde da placenta. Algumas delas são tão pequenas que, após a inalação, podem entrar na corrente sanguínea e serem entregues diretamente na placenta ou no feto.”
A ligação foi mais forte e precisa no oeste dos EUA, onde as pessoas foram expostas às maiores concentrações de incêndios florestais, PM2,5e o maior número de dias de fumaça de alta intensidade. Aqui, as chances de nascimento prematuro aumentaram com cada micrograma adicional por metro cúbico de PM média de incêndios florestais2,5.
É possível que esses resultados tenham sido mais precisos simplesmente porque o Ocidente experimenta, em média, mais fumaça de incêndio florestal, fazendo com que o modelo de exposição tenha um desempenho melhor, disse Sherris. Mas pode haver outros factores por detrás das diferenças regionais.
A composição da fumaça dos incêndios florestais é diferente em todo o país. No Ocidente, a fumaça tende a vir de incêndios próximos, enquanto em lugares como o Centro-Oeste, a fumaça normalmente vem de incêndios distantes. A toxicidade da fumaça muda à medida que envelhece e reage com a luz solar e produtos químicos transportados pelo ar, o que pode ter afetado os resultados. Os pesquisadores também observaram que fatores externos, como o calor concomitante ou a qualidade da habitação, podem ter efeitos que não são totalmente compreendidos.
Os pesquisadores esperam que estudos futuros examinem os mecanismos exatos pelos quais a fumaça dos incêndios florestais pode desencadear o nascimento prematuro. Mas entretanto, disse Sherris, as provas de uma ligação são agora suficientemente fortes para tomar medidas.
“Existem alguns caminhos para mudança”, disse Sherris. “Em primeiro lugar, as pessoas já recebem muitas mensagens e informações de saúde pública durante a gravidez, por isso há uma oportunidade de trabalhar com os médicos para fornecer ferramentas às grávidas para se protegerem durante eventos de fumo. As mensagens das agências de saúde pública sobre o fumo dos incêndios florestais também podem ser adaptadas às pessoas grávidas e destacá-las como um grupo vulnerável”.
Mais informações:
                                                    Allison R. Sherris et al, Material particulado fino específico para incêndios florestais e nascimento prematuro: uma análise de coorte ECHO dos EUA, Saúde Planetária da Lancet (2025). DOI: 10.1016/j.andopl.. www.thelancet.com/journals/lan… (25)00202-5/texto completo
Citação: Exposição à fumaça de incêndio florestal durante a gravidez associada a maior risco de parto prematuro (2025, 3 de novembro) recuperado em 3 de novembro de 2025 em
Este documento está sujeito a direitos autorais. Além de qualquer negociação justa para fins de estudo ou pesquisa privada, nenhuma parte pode ser reproduzida sem permissão por escrito. O conteúdo é fornecido apenas para fins informativos.
Share this content:

Publicar comentário